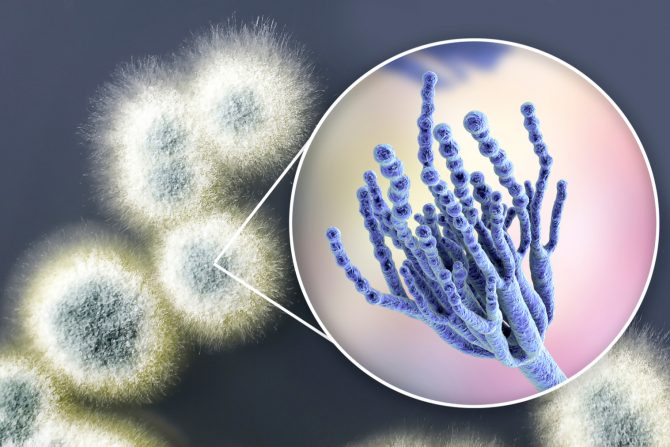
alergija na penicilin

Alergija na penicilin može da bude samo osip, ali i životno opasna uz anafilaktički šok
U retkim situacijama, alergijska reakcija na primenu penicilina može da se pojavi čak i danima ili i nedeljama nakon što smo primili lek
Alergija na penicilin događa se kada naše telo prepozna ovaj antibiotik kao alergen. Telo reaguje tako što se naš imunski sistem brani, stvarajući antitela. Obično su to IgE antitela, iako mogu da reaguju i druga.
Alergija na penicilin: od kožnih reakcija do anafilakse
Imunski odgovor kao reakcija na penicilin može da se javi i nezavisno od IgE antitela. Drugi imuni proteini, kao što su imunoglobulin G, imunoglobulin M, ili druge imune ćelije kao što su T ćelije, takođe mogu da pokrenu odgovor organizma. U zavisnosti od toga koja antitela se „probude“, dolazi do oslobađanja hemikalija koje dovode do ispoljavanja simptoma.
Njihov spektar je različit. Kreću se od koprivnjače i kratkog daha, do anafilakse, koja može da bude životno ugrožavajuće stanje. Statistike kažu da se preosetljivost na penicillin javlja u procentu od 1-10 pacijenata sa reakcijom. Do anafilaktičkog šoka (anafilakse), kao potencijalno najopasnija reakcije, dolazi u oko 0,05 odsto slučajeva.
Koji su simptomi kada se pojavi alergija na penicilin
Ukoliko se aktivira imunoglobulin E (IgE), određeni simptomi se mogu pojaviti odmah, ili u roku od sat vremena. To su:
- kožni osip (sa višestruko upaljenim, izdignutim, crvenim, podignutim površinama kože)
- angioedem (lokalizovana područja otoka bez osipa na licu, stomaku, genitalijama, jeziku, grlu, rukama ili nogama)
- kratak dah i pištanje u grudima
- anafilaksa
Još neke vrste rekcija na penicilin su uobičajene. To su pre svega alergije odloženog tipa. One mogu da izazovu osip koji svrbi i koji se možda neće pojaviti i do nekoliko dana od početka uzimanja penicilinskih antibiotika. Postoji i vrsta alergije slična serumskoj bolesti, pri kojoj se, pored ostalih simptoma, može pojaviti osip po telu, uz temperaturu i umor.
Alergija na penicilin i podela prema vremenu od unošenja leka
Prema vremenu koje je prošlo od uzimanja leka do simptoma alergijske reakcije, one se dele na:
- rane: reakcija koja nastaje u prvom satu od uzimanja leka. Po intenzitetu, one su i najburnije i najozbiljnije, a mogu da dovedu do anafilaktičkog šoka, edema, gušenja, urtikarije, angioedema. Najveći broj fatalnih ishoda uzrokovale su upravo ove reakcije.
- ubrzane: događaju se u periodu od prvog do sedamdeset drugog sata nakon što smo dobili lek. Najčešći simptomi su kožne reakcije poput urtikarije, kao i edemi (larinksa, angioedem). Fatalni ishodi su retki kod ove grupe reakcija.
- kasne: praćene su kožnim promenama (osip), visokom temperaturom i bolom u zglobovima ruku i nogu. Javljaju se sedamdeset dva časa od uzimanja penicilina ili srodnog antibiotika.
Inače, ako imamo kasnu reakciju, moguće je da ne postoji kontraindikacija za peniclin i da je razlog reakcije nešto drugo. Svakako je važno obratiti pažnju na ovaj simptom, jer može da dođe do sličnih problema u budućnosti, pa i ozbiljnijih posledica (čak i do anafilakse).
Da li alergija na penicilin može da se javi i nakon prestanka uzimanja leka
U retkim situacijama, alergijska reakcija na primenu penicilina može da se pojavi čak i danima ili i nedeljama nakon što smo primili lek. Takođe, zanimljivo je neke reakcije mogu da se jave, pa i da traju i nakon što potpuno prestanemo da uzimamo lek. U njih spadaju:
- serumska bolest (simptomi su povišena temperaturu, bol u zglobovima, edemi, osip, mučnina)
- anemija (spada u anemije prouzrokovane lekovima, a posledice su opadanje broja crvenih krvnih zrnaca, hronični umor, nepravilan rad i promena srčanog ritma, otežano ili plitko disanje)
- reakcije na uzimanje drugih lekova (simptomi su eozinofilija, osip, visoki eritrociti, edemi, otečenim limfni čvorovi)
- nefritis (upala bubrega sa povišenom temperaturom, edemima po celom telu, hematurijom (pojava krvi u mokraći), konfuznim stanjem
- toksična epidermalna nekroliza (bolest poznata kao Stevens-Johnsonov sindrom, sa velikim plikovima, ljuštenjem kože i ranama).
Postavljanje dijagnoze
Alergija na penicilin se dijagnostikuje anamnezom, kliničkom slikom (ustanovljavanjem realnih simptoma) i testovima. Lekari koriste kožne, intradermalne testove i lekove za dijagnozu određenih vrsta alergija na penicilin. Bilo koji tip alergije na penicilin može da se konstatuje isključivo na osnovu kliničke istorije osobe i fizičkog pregleda.
Lečenje alergije na penicilin
Lečenje blagih slučajeva može da ublaži, pa i reši uzimanje antihistaminika. U teškim slučajevima, može da bude potrebna hitna primena epinefrina, uz još neke lekove. Ukoliko se otkrije da je pacijent alergičan na penicilin, postoji rizik i da je alergičan i na neke lekove slične penicilinu. Međutim, to ne mora da bude slučaj. Ipak, jedini način da se spreče alergijske reakcije na penicilin jeste izuzimanje ovog antibiotika iz primene u lečenju pacijenta.
Kako alergija na penicilin može da utiče na naše organe
Anafilaksa je stanje opasno po život koje se može javiti odmah, ili u roku od sat vremena nakon uzimanja penicilina. Inače, simptomi alergije na penicilin mogu da utiču na sledeće sisteme naših organa:
- koža (osip, angioedem, crvenilo, svrab)
- respiratorni sistem (kašalj, kratak dah, pištanje i stezanje u grudima, začepljenost nosa, osećaj gušenja ili zatvaranja grla)
- gastrointestinalni sistem (mučnina, povraćanja, dijareja, bol u stomaku)
- kardiovaskularni sistem (ubrzani rad srca, nizak krvni pritisak ili osećaj nesvestice - pojedinačno ili udruženo); ređi simptomi su bol u grudima, efekat tunela u vidnom polju ili defetistička osećanja).
Da li alergija na penicilin prolazi ili traje do kraja života
Ljudi obično dobijaju dijagnozu alergije na penicilin u detinjstvu. Faktori rizika za IgE alergijsku reakciju jesu ponovljene ili česte doze penicilina. Kada se osip povezan sa uobičajenim infekcijama u detinjstvu poklopi sa davanjem antibiotika tipa amoksicilina ili penicilina, lekari mogu da prekinu davanje antibiotika i sugerišu izbegavanje kao meru predostrožnosti.
Istraživanja kažu da će od ljudi koji su imali potvrđenu alergiju na penicilin, njih preko 90 odsto izgubiti u periodu od 10 godina. Međutim, bez dalje, ponovljene procene moguće alergije na antibiotike, ljudi obično ovu dijagnozu ne dovode u pitanje, i tretiraju je kao konstantno stanje.
Desenzibilizacija u slučaju alergije na penicilin
Ponekad, međutim, ne postoji drugi antibiotik osim penicilina koji bi bio efikasan za lečenje infekcija kod nekih osoba.
Ukoliko njihov alergijski odgovor ukazuje na reakciju IgE antitela, rešenje bi moglo da bude desenzibilizacija. To je proces u kome osoba prima postepeno veće doze penicilina, sve do maksimalne tolerancije na određenu dozu. Desenzibilizacija se sprovodi doziranjem u oralnom obliku, davanjem injekcije u venu, ili potkožno. Ovaj vid terapije deluje samo kod alergija koju su aktivirala IgE antitela.
eKlinika zadržava sva prava nad sadržajem. Za preuzimanje sadržaja pogledajte uputstva na stranici Uslovi korišćenja.


